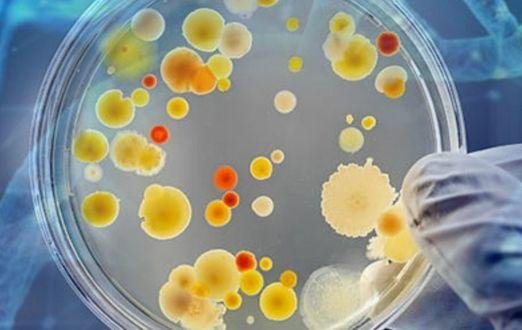
bacteria-testing.jpg

961883179124/7 Support Center
Our organization specializes in delivering highly accurate Bacterial, Fungal and Yeast testing services, covering both standard and customized analytical methods. All tests are conducted at our fully automated and computerized laboratory, ensuring precision, reliability, and fast reporting. We excel in molecular identification of microorganisms, including Bacteria, Archaebacteria, Fungi, Algae With an extensive experience of handling over 5000 microbial identification samples, we ensure scientific accuracy and traceability in every report. Our strength lies in faster turnaround time, advanced analytical techniques, and detailed result documentation.